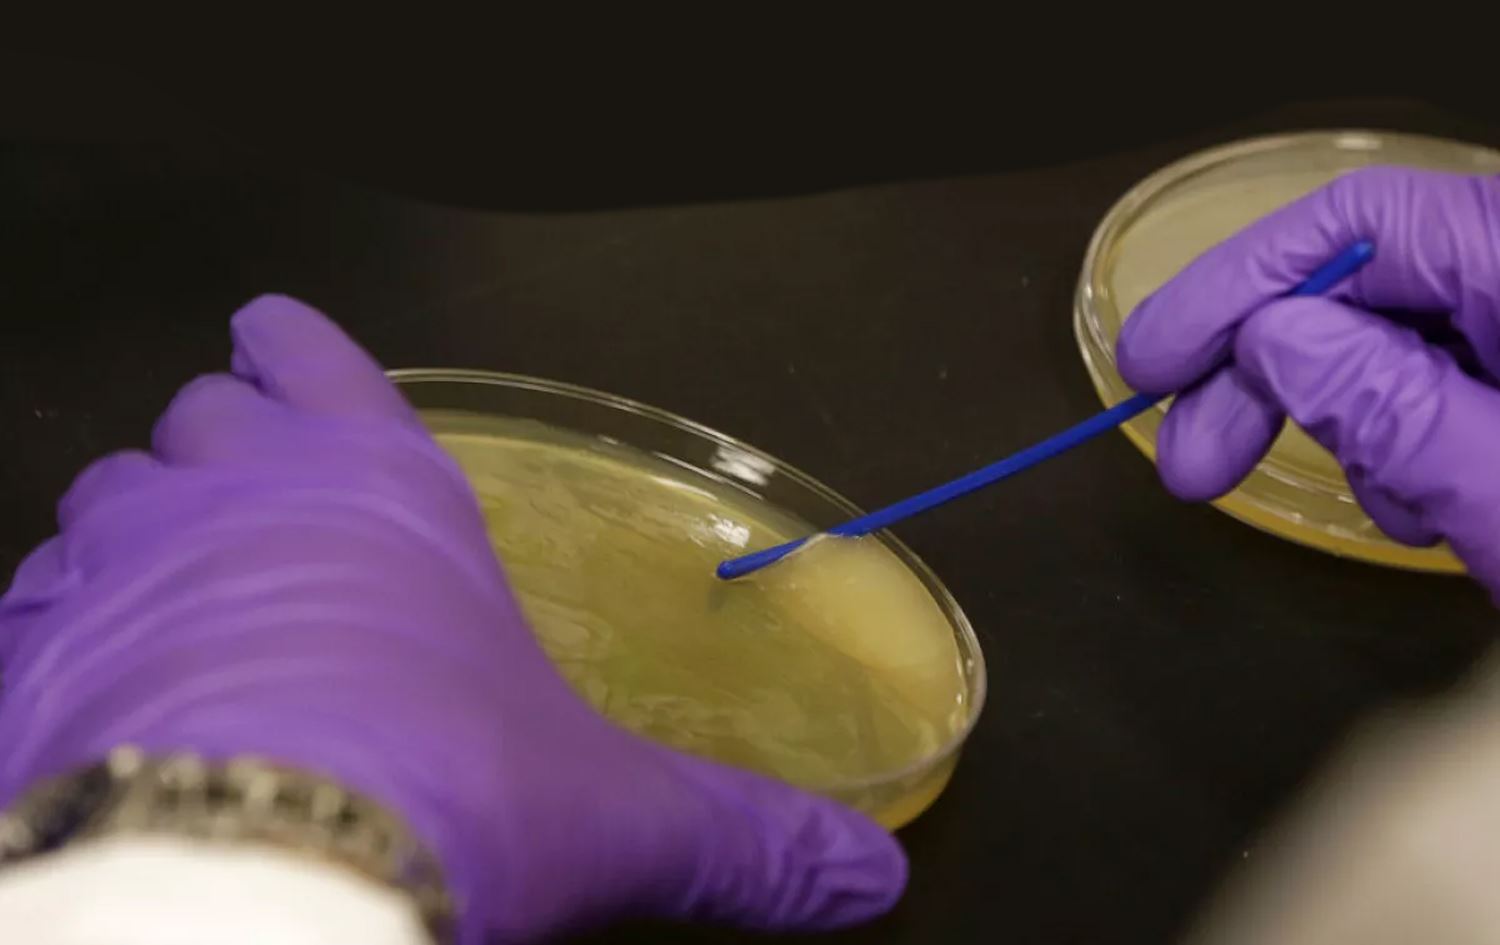

Haber Merkezi - Japonya'da nadir bir "et yiyen" bakteri hızla yayılmaya başladı.
Streptokok A bakterisinin çocuklarda streptokok boğaz ağrısına neden olduğu bilinirken bakterinin daha şiddetli bir formu yayıldıkça endişe yaratmaya başladı.
Japonya, 941 doğrulanmış streptokok toksik şok sendromu (STSS) vakasıyla, en ölümcül streptokok türünün rekor seviyelerini gördü. 2024'ün ilk iki ayında kaydedilen ve Japonya'nın 47 vilayetinden ikisi hariç hepsini etkileyen 378 vakanın ardından enfeksiyonların bu rekoru da aşması bekleniyor.
Japan Times'ın haberine göre, A grubu streptokok hastalığının bu en şiddetli formunun her yıl ortalama 200 vakası görülmekte.
Uzmanlar enfeksiyonlardaki artışa neyin sebep olduğunu bilmediklerini itiraf ettikleri için korkuların da artmaya başladığı belirtildi.
Ulusal Bulaşıcı Hastalıklar Enstitüsü (NIID) sözcüsü, "Şiddetli ve ani başlangıçlı streptokok formlarıyla ilgili hala bilinmeyen birçok faktör var. Olanları açıklayabilecek aşamada değiliz" dedi.
Virüs, boğazda, ciltte, anüs ve cinsel organlarda yaşayan ve büyüyen bir bakteri olarak açıklanıyor. Grup A streptokok, ilgili bakteri türüne bağlı olarak cildi, yumuşak dokuyu ve solunum sistemini etkileyen bir dizi hastalığa neden olabiliyor. Bu hastalıklara bademcik iltihabı, farenjit, kızıl, impetigo, erizipel ve zatürre de dahildir.
Tekrarlanan strep A enfeksiyonları, romatizmal kalp hastalığı olarak bilinen, kalpte otoimmün hasara neden olabilmekte. Bu durum dünya çapında çoğu düşük ve orta gelirli ülkelerde yaşayan yaklaşık 50 milyon insanı etkiliyor.
Şiddetli strep A vakaları her yıl yaklaşık yarım milyon insanı öldürüyor.

Yorumlar
Misafir olarak yorum yazın ya da daha etkili bir deneyim için oturum açın
Yorum yazın